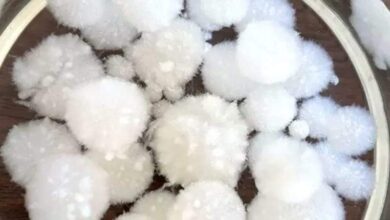

علا خالد
-
حوادث
القبض على طرفى مشاجرة بالقاهرة
متابعة: محمد قدرىتمكنت قوة قسم شرطة النزهة بمديرية أمن القاهرة القبض على أشخاص قاموا بحدوث مشاجرة أمام (أحد مكاتب توصيل…
قراءة المزيد -
حوادث
مفاجأة إعصار فيونا “التاريخي”
متابعة/رحمه عقلقُطع التيار الكهربائي عن مئات الآلاف من الأشخاص في كندا، مع وصول الإعصار فيونا إلى الساحل الأطلسي للبلد. وتشهد…
قراءة المزيد -
مقالات
تعرف على أكثر متاحف العالم سرية
متابعة/رحمه عقل يحتوى المتحف السري لوكالة الاستخبارات الأمريكية “سي آي إيه”على قطع أثرية أسهمت في تشكيل التاريخ. لكن أبواب هذا…
قراءة المزيد -
منوعات
الدقيق المصنوع من الفطر والقرنبيط أفضل من دقيق القمح
متابعة/رحمه عقل شرعت المهندسة الكيميائية التي تتخذ من شيكاغو مقراً لعملها، في تحسين ليس صحة أسرتها فقط، بل صحة الناس…
قراءة المزيد -
منوعات
تعرف على تطور الخبز عبر السنين
متابعة/رحمه عقلاكتشف علماء أقدم دليل ملموس على صنع الخبز، من موقع حفر عمره 14 ألف عام. العلماء قالوا إن ما…
قراءة المزيد -
مدارس وجامعات
وزير التعليم العالي يستقبل مدير اليونسكو للعلوم لبحث التعاون المُشترك
متابعة/علا خالد استقبل د. أيمن عاشور وزير التعليم العالي والبحث العلمي، رئيس اللجنة الوطنية المصرية للتربية والعلوم والثقافة “اليونسكو”، د.…
قراءة المزيد -
عرب وعالم
وزير الصحة يستقبل سفير فرنسا لدى مصر لبحث تعزيز التعاون بين البلدين في القطاع الصحي
متابعة/علا خالد استقبل الدكتور خالد عبدالغفار وزير الصحة والسكان، أمس الأحد، السيد مارك باريتي سفير فرنسا لدى مصر، والوفد المرافق…
قراءة المزيد -
حوادث
عطل مفاجئ في محولات الكهرباء يتسبب في نقل 20 مريضًا من مستشفى سوهاج العام
كتب /عبدالرحمن الجن شهدت مستشفى سوهاج العام انخفاضًا ملحوظًا وضعفًا في التيار الكهربائي، نتيجة حدوث عُطل مفاجئ في محولات الكهرباء…
قراءة المزيد -
حوادث
مصرع مزارع سقط من فوق نخلة بدار السلام
كتب / عبدالرحمن الجن لقى مزارع في العقد السابع من العمر مصرعه، إثر سقوطه من أعلى نخله، أثناء قيامه بعملية…
قراءة المزيد -
رياضة
الزمالك يتأهل لنهائي البطولة العربية للأندية لكرة اليد النسخة ٣٧ رجال
متابعة : شريف صلاح الدينحقق الفريق الأول لكرة اليد بنادي الزمالك بقيادة الاسباني ماتيو جارالدا الفوز علي فريق الكويت الكويتي…
قراءة المزيد